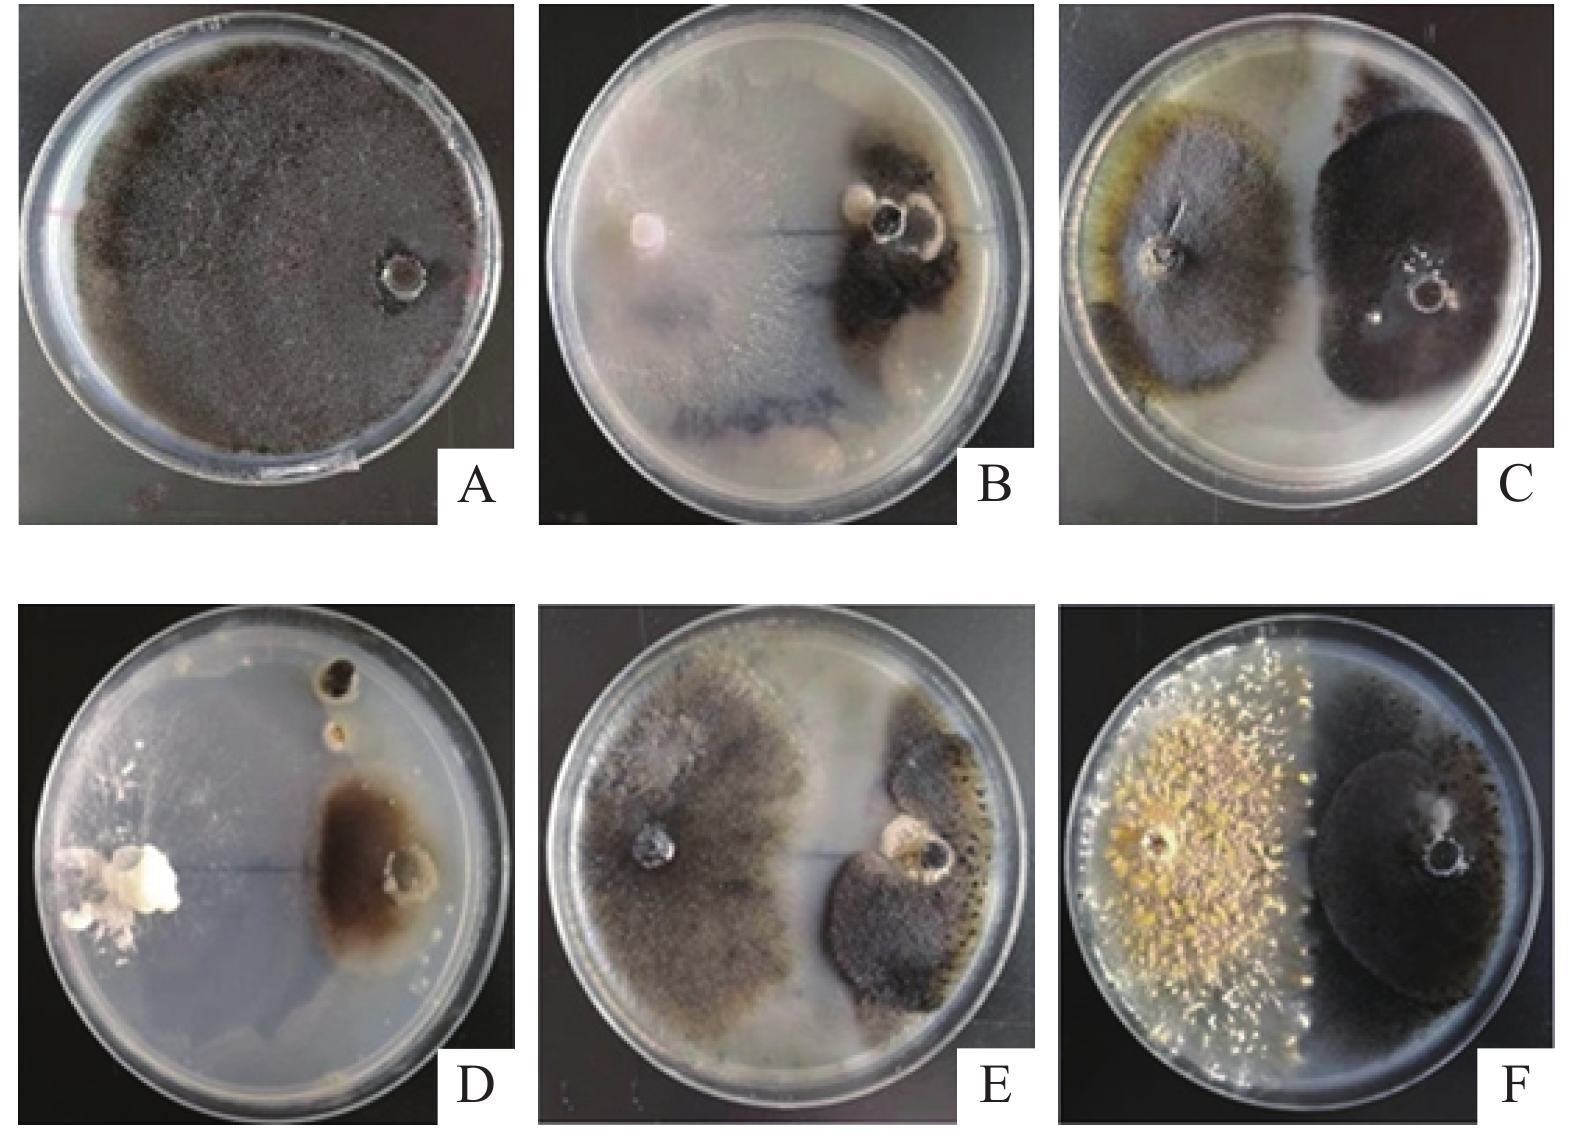

2. 广州中医药大学 基础医学院,广东 广州 510006
2. School of Basic Medical Sciences, Guangzhou University of Chinese Medicine, Guangzhou 510006, China
铁皮石斛Dendrobium officinale 是隶属于兰科Orchidaceae石斛属Dendrobium的多年生附生草本植物,为我国传统名贵中药[1]。铁皮石斛入药部分是其新鲜或干燥茎, 具有益胃生津、滋阴清热的功效[1]。已有研究表明,铁皮石斛的主要活性成分(如石斛多糖、生物碱等)具有降血糖、降血脂、降血压、提高机体免疫力的作用,其在医药保健方面应用越来越广,需求量急剧上升[2]。但铁皮石斛的种子极小、无胚乳, 自然条件下萌发率低,实生苗栽培较难, 再加上人为过度采挖及生境破坏,野生铁皮石斛资源已濒临灭绝[3]。目前铁皮石斛主要来源于人工栽培,但人工栽培植株脱离原有生态环境, 药材品质与野生型存在一定的差异。汪群红等[4]研究表明,野生铁皮石斛茎中多糖含量和总氨基酸含量优于人工栽培植株。而且人工种植过程中,铁皮石斛较易受到微生物病害的侵染。由病原真菌胶孢炭疽菌Colletotrichum gloeosporioides侵染所致的炭疽病是铁皮石斛种植过程中的严重病害之一,它主要引起植株叶片圆形或类圆形凹陷性枯萎,可造成铁皮石斛减产和品质降低[5]。因此,如何提高人工栽培铁皮石斛的药材品质以及有效防治种植过程中的炭疽病已成为铁皮石斛产业面临的重要课题。
植物内生菌是指在植物中度过全部或部分生命周期, 对宿主植物产生一定间接或直接作用,一般不引起植株病害的一类微生物, 主要包括真菌和细菌[6]。宿主植物可为内生菌提供生存所需的环境、营养和能量等,同时内生菌依靠自身的生命代谢活动对宿主植物产生影响[7]。已有大量研究表明内生菌具有促进植物生长、增强宿主氮吸收、提高植物抗逆性及抗病性等作用[8]。也有研究结果表明药用内生真菌可以提高药用植物的主要药用活性成分,与其道地性的形成密切相关[9]。但目前对于野生型与人工栽培型铁皮石斛内生真菌的比较缺乏系统研究,而且关于内生真菌对铁皮石斛炭疽病的生物防治研究也鲜有涉及[10]。因此,本研究拟系统分析不同生境下铁皮石斛(野生型和人工种植栽培型)内生真菌多样性,获得其差异类群数据,并从中筛选具有对石斛炭疽菌具有抑制作用的活性菌株,从而为应用内生真菌于人工栽培铁皮石斛品性改良及炭疽病的生物防治奠定基础。
1 材料与方法 1.1 药用植株野生铁皮石斛(6株),采集自广东省清远 (23°20′49″N, 113°12′ 11″E),其株高10~15 cm,生长状态良好;人工栽培铁皮石斛(6株)采集自饶平铁皮石斛人工种植基地(23°10′49″N,113°21′9″E),株高20~35 cm,生长状态良好。采样时将整株植物挖出,用无菌塑料袋装好,放入冰盒中运送至实验室, 再置于4 ℃冰箱保存, 2 h内进行内生真菌的分离。
1.2 培养基和试剂马铃薯葡萄糖琼脂(PDA)培养基购自于广东环凯。T5×2 Premix(Tsingke)购自于广东擎科生物;真菌基因组提取试剂盒(Magen)购自于上海玉博生物有限公司;引物ITS1(5′-TCCGTAGGTGAACCTGCGG-3′)和ITS4(5′-TCCTCCGCTTATTGATATGC-3′)由华大基因合成。
1.3 试验菌株本研究使用的致植物炭疽病的炭疽菌为半知菌亚门Deuteromycotina腔孢纲Coelomycetes黑盘孢目Melanconiales炭疽菌属Colletotrichum胶孢炭疽菌C. gloeosporioides, 由广州中医药大学药学院张桂芳老师提供。
1.4 内生真菌的分离和纯化参考文献[11]的方法对铁皮石斛植株进行内生真菌的分离与纯化:用自来水冲洗掉铁皮石斛植株上的泥土后,将其根、茎、叶剪切成约2 cm的小段, 依次浸泡在体积分数为75%的乙醇溶液2 min, NaClO溶液(10.91~ 65.45 g/L)5 min,无菌水冲洗3遍或以上, 晾干后将其剪成约0.5 cm×0.5 cm的小片置于PDA平板上, 28 ℃条件下培养2~4周。待菌丝从组织块切口处长出, 挑出菌丝转接到新的PDA平板上,2~3次纯化后保存。同时收集表面消毒时最后1次冲洗样品的水样,进行消毒效果的检测。
1.5 内生真菌的鉴定采用载玻片法[11]培养真菌, 在显微镜下观察真菌的菌丝、孢子及子实体结构, 同时结合其菌落特征进行分类。应用真菌基因组DNA kit(Magen)完成真菌DNA提取工作。以提取的内生真菌DNA为模板,扩增rRNA内转录间隔区基因(Internal transcribed spacer regions of ribosomal DNA, rDNA-ITS);10 g/L的琼脂糖凝胶电泳(80 V,30 min)鉴定PCR产物后,送上海美吉生物有限公司测序,最后将测序序列在Blast(
采用平板对峙法将胶孢炭疽菌和内生真菌转接到PDA板上,28 ℃条件下活化培养,7 d后用打孔器获取0.5 cm×0.5 cm的菌饼;以单接胶孢炭疽菌菌饼的PDA板为对照组,3次重复;试验组中内生真菌菌饼和胶孢炭疽菌菌饼接种在同一PDA板上,2个菌饼中心连线过PDA板中点,间距为5.5 cm,每种拮抗菌做3次重复;所有菌株在28 ℃恒温环境下培养,每天观察菌株生长情况;在第7天测量对照组胶孢炭疽菌生长半径和试验组胶孢炭疽菌指向内生真菌方向的菌株半径。按下列公式计算内生真菌对胶孢炭疽菌的抑菌率:抑菌率= (病原菌对照菌落半径−病原菌指向拮抗菌半径) /病原菌对照菌落半径× 100%。
1.7 数据处理参考文献[11]的方法对野生和人工种植铁皮石斛内生真菌的定殖率 (Colonization rate, CR)、分离率(Isolation frequency, IF)、相对分离频率 (Relative frequency, RF)、Shannon-Wiener多样性指数 (H')、均匀度指数 (E)、相似性指数 (C) 进行计算及分析。采用Excel、SPSS软件进行数据整理统计,利用Duncan’s法分析铁皮石斛不同部位的定殖率、分离率、多样性指数等是否存在差异, 采用t检验分析不同生境下的数据是否存在差异。
2 结果与分析 2.1 野生与人工栽培铁皮石斛内生真菌的分离将最后一遍冲洗石斛样品的水样涂布PDA平板, 28 ℃条件下培养14 d后无菌落生长。将从根、茎、叶分离出的内生真菌各取5株代表性真菌菌丝体进行相同程序的表面消毒后置于PDA平板上培养, 14 d后未见真菌生长。以上结果表明, 表面消毒过程已将样品表面的附生菌消除, 分离到的菌株来自于样品内部, 属于铁皮石斛内生真菌。
如表1所示,本研究从432个铁皮石斛组织块中分离到236株内生真菌,其中132株来自野生铁皮石斛,104株来自人工栽培铁皮石斛。野生植株内生真菌在茎中的定殖率最高(72.22%),其次为根部(56.94%),而叶的定殖率最低(22.22%),各部位内生真菌的分离率与定殖率呈现相同的变化规律, 分离率从高到低依次为茎 (86.11%)、根(68.06%)、叶(29.17%)。人工栽培植株内生真菌在叶中的定殖率最高(50.00%),其次为茎部(43.06%),而根的定殖率最低(25.00%),各部位内生真菌的分离率从高到低依次为叶 (55.56%)、茎 (55.56%)、根(33.33%)。野生样品内生真菌总定殖率和总分离率均高于人工栽培植株,具体到部位,野生型植株内生真菌的根、茎的定殖率和分离率显著高于人工栽培植株,而叶部则相反,人工栽培植株叶部内生真菌的定殖率和分离率显著高于野生型。
|
|
表 1 铁皮石斛内生真菌的定殖率和分离率1) Table 1 The colonization rate and isolation rate of endophytic fungi in Dendrobium officinale |
本研究从野生和人工栽培铁皮石斛中共分离到236株内生真菌,先利用菌落形态、孢子及子实体结构对其进行分类,然后从各类中挑出1~4株典型菌株进行分子鉴定,综合分析结果显示,它们分属于30个属,具体列于表2。
|
|
表 2 代表性铁皮石斛内生真菌的分子鉴定 Table 2 Molecular identification of representative endophytic fungi from Dendrobium officinale |
如表3所示,野生植株中共分离到132株菌,属于24个属,其优势类群为硬孔菌属Rigidoporus(12.88%)、显革菌属Phanerochaete(10.61%)、短梗霉属Aureobasidium(9.85%)、栓菌属Trametes(9.09%)、裂褶菌属Schizophyllum(8.33%)、炭疽菌属(6.82%)、青霉属Penicillium(4.55%)和蜡孔菌属Ceriporia(4.55%)。野生铁皮石斛各部位内生真菌类群分布存在明显的差异:根部内生真菌属于18个属,其优势类群为裂褶菌属(16.33%)、硬孔菌属(14.29%)、短梗霉属(10.20%)、栓菌属(10.20%)、蜡孔菌属(8.16%)、显革菌属(6.12%)、蚁巢伞属Termitomyces(6.12%)、隔孢伏革属Peniophora(6.13%);茎部分离到19个属,其优势类群为硬孔菌属(12.90%)、显革菌属(12.90%)、炭疽菌属(12.90%)、短梗霉属(8.07%)、拟茎点霉属Phomopsis(6.45%)、栓菌属(6.45%);叶部共分离到11个属,优势菌群为短梗霉属(14.29%)、显革菌属(14.29%)、栓菌属(14.29%)、子囊菌属Ascomycota(14.29%)、硬孔菌属(9.52%)、青霉属(9.52%)。硬孔菌属、短梗霉属、显革菌属和栓菌属这4个属在根、茎、叶均为优势菌属,隔孢伏革属、拟层孔菌属、酵母属Meyerozyma和Subulicystidium只在根中分布,而伏革菌属Phlebiopsis、曲霉属Aspergillus、茎点霉属Phoma和浅黄囊孔属Flavodon只在茎中分布,间座壳属Diaporthe只在叶中有分布。
|
|
表 3 铁皮石斛根、茎、叶中内生真菌不同属的占比 Table 3 Genus proportions of endophytic fungi in roots, stems and leaves of Dendrobium officinale |
从人工栽培样品根、茎、叶中总共分离到104株内生真菌,经鉴定归为16个属(表3),其优势类群为镰刀菌属(21.14%)、青霉属(11.54%)、木霉属Trichoderma(11.54%)、曲霉属(9.62%)、耙齿菌属(9.62%)。人工植株各部位的内生真菌类群结构也存在较大的差异:根部内生真菌分属于8个属,其优势类群为木霉属(25.01%)、曲霉属(16.67%)、青霉属(16.67%);茎部内生真菌分为10个属,优势类群为镰刀菌属(45.00%)、耙齿菌属(15.00%);叶中共分离到12个属,优势菌属为青霉属(15.00%)、镰刀菌属(10.00%)、曲霉属(10.00%)、木霉属(10.00%)、耙齿菌属(10.00%)、显革菌属(10.00%)和Grammothele(10.00%)。曲霉属、青霉属、木霉属、踝节菌属Talaromyces在根、茎、叶均有分布;镰刀菌属、耙齿均属、显革菌属只分布在茎、叶部;栓菌属、裂褶菌属、隔孢伏革属只分布在根和叶部;硬孔菌属只在根部分布;新梭孢属Neofusicoccum、赤霉菌属、Pilatoporus只在茎部分布;Grammothele、炭疽菌属只在叶部分布。
2.3 铁皮石斛不同部位内生真菌的多样性和相似性比较由表4可知,野生铁皮石斛内生真菌的多样性指数(H′)为2.95,根、茎、叶的内生真菌H′分别为2.70、2.82、2.28,茎中内生真菌多样性最高;根、茎、叶的均匀度指数(E)分别为0.92、0.94、0.95,统计无显著差异,3个部位内生真菌类群分布均匀。野生植株中茎与根相似性最高(C茎−根=0.72),其次是茎与叶的相似性(C叶−茎=0.65),根与叶的相似性最低(C根−叶=0.60);根据Jaccard相似性系数原理判断标准,野生铁皮石斛根、茎、叶3个部位两两之间的内生真菌类群组成均为中等相似。人工栽培铁皮石斛内生真菌的H′为2.49,根、茎、叶的内生真菌H′分别为1.98、1.84、2.42;根、茎、叶的E分别为0.95、0.80、0.97,说明叶中的内生真菌多样性最高,且类群最均匀,茎中多样性指数最低,且类群最不均匀;人工栽培植株中根与叶相似性最高(C根−叶=0.70),其次是茎与叶的相似性(C叶−茎=0.64),根与茎的相似性最低(C根−茎=0.44);根据Jaccard相似性系数原理判断标准,人工栽培铁皮石斛植株内生真菌类群在根叶和茎叶中均为中度相似,根茎中为中度不相似。
|
|
表 4 铁皮石斛根、茎、叶中内生真菌的多样性1) Table 4 The diversity of endophytic fungi in roots, stems and leaves of Dendrobium officinale |
图1为胶孢炭疽菌与铁皮石斛内生真菌共培养7 d后的部分菌落形态。通过共培养试验,从内生真菌中筛选到34株对胶孢炭疽菌具明显拮抗效应的菌株(表5),它们对胶孢炭疽菌的抑制率均超过 50%。这34株菌分属于20个属,其中占比最高的是显革菌属(11.76%),其次为裂褶菌属(8.82%)和拟茎点霉属(8.82%)。菌株F102(蜡孔菌Ceriporia sp.)、F27(硬孔菌Rigidoporus sp.)、F103(蚁巢伞菌Termitomyces sp.)和F122(伏革菌Peniophora sp.)对胶孢炭疽菌的抑制效果较好,其抑菌率分别达到93.06%、88.20%、87.48%和84.57%。
|
图 1 铁皮石斛内生真菌对胶孢炭疽菌生长的影响 Fig. 1 The effects of fungal endophytes from Dendrobium officinale on the growth of Colletotrichum gloeosporioides A为胶孢炭疽菌株生长7 d后的菌落形态;B、C、D、E、F分别为胶孢炭疽菌株与F84、F123、F31、F100、F05菌株共培养7 d后的菌落形态 A shows the colony morphology of C. gloeosporioides strains growing for 7 days; B, C, D, E and F are the colony morphologies of C. gloeosporioides growing with strains F84, F123, F31, F100 and F05, respectively, for 7 days |
|
|
表 5 野生铁皮石斛内生真菌对胶孢炭疽菌的抑制作用1) Table 5 Inhibitory effects of endophytic fungi of wild Dendrobium officinale on Colletotrichum gloeosporioides |
本研究发现野生铁皮石斛内生真菌的总体定殖率、分离率及多样性指数均高于人工栽培植株。由于植物内生菌主要来源于环境微生物,因而这可能是两者的生境不同导致的:野生铁皮石斛多生长在气候湿润、植被丰富的山地环境中,周边及土壤中微生物多样性丰富[12-13],而大棚环境下的人工栽培植株的物种较为单一,栽培基质经过消毒等处理,因而其生长环境的微生物多样性较低[14]。虽然野生型植株内生真菌总体分离率和定殖率高于人工栽培型,但人工栽培植株叶部的内生真菌分离率和定殖率却高于野生型。与根、茎相比,植物叶部内生真菌的重要来源是空气微生物[15],而且叶部表面积大,叶部内生真菌丰度受周边环境条件(湿度、温度)影响更直接。人工栽培环境下植株水的喷洒量大,环境湿度和温度更稳定,从而导致人工栽培植物叶部被水携带的空气真菌侵染的几率更大,湿度和温度也更利于真菌在叶部的繁殖,因而其分离率和定殖率相对于野生型更高。也有研究发现人工栽培植株和野生型植株叶部的化学成分(多糖、氨基酸和生物碱)存在一定差异,这些差异成分也可能有利于内生真菌在其体内的定殖[4-16]。有研究表明,道地药材在其特定生境中形成的内生菌群可以通过影响宿主植物药用活性物质的合成,从而参与到药材道地性的形成过程[17]。本研究结果发现,野生型铁皮石斛内生真菌类群结构与人工栽培植株具有较大的差异:野生植株的优势菌群为硬孔菌属等,人工栽培植株的优势菌群为镰刀菌属等。隔孢伏革属、拟层孔菌属和酵母属、Subulicystidium只在野生铁皮石斛根部分离到,伏革菌属、曲霉属、茎点霉属、浅黄囊孔属只在野生铁皮石斛茎中分离到,间座壳属只在野生铁皮石斛叶中分离到。这些野生型铁皮石斛与人工栽培植株内生真菌类群的差异信息将为人工栽培铁皮石斛的药材品质的改良提供前期基础。
胶孢炭疽菌是引起珠三角地区人工栽培铁皮石斛炭疽病的主要菌株[5]。目前对于棚栽区炭疽病主要采用化学农药等进行防治[5]。化学农药虽然具有一定的防治效果,但病菌容易产生耐药性,防治效果并不稳定,而且还容易造成农药残留,影响石斛的质量,因此急需寻找新的安全有效的石斛炭疽病防治方法[18]。内生真菌可与宿主植物形成紧密的共生关系,并对其产生持续、稳定的作用。已有研究发现,内生真菌可通过多种机制提高植物抵抗生物病害的能力,并已成功应用到多种植物病害的防治研究中,如内生菌Epicoccum nigrum ASU11可降低马铃薯黑腐病的严重程度[19],小麦根部内生菌链霉菌Streptomyces sp. DEF 09菌株可使小麦赤霉病严重程度降低60%[20],因此内生真菌在植物病害的生物防治中具有良好的应用前景。本研究从铁皮石斛中筛选到34株具有拮抗炭疽菌的内生真菌,它们对胶孢炭疽菌的抑制率均高于50%,其中菌株Ceriporia sp. F102、Rigidoporus sp. F27、Termitomyces sp. F103和Peniophora sp. F122的抑菌效果较好,其抑菌率分别为93.06%、88.20%、87.48%和84.57%。这些菌株将为铁皮石斛炭疽病的生物防治提供潜在的生防菌资源,其在田间的生防效果有待后续进一步研究。
| [1] |
曹会群. 铁皮石斛质量标准提升及不同加工方法产品的质量比较研究[D]. 贵阳: 贵阳中医学院, 2017.
(  0) 0) |
| [2] |
李毓扬, 吕承豪, 吴广, 等. 铁皮石斛干预代谢综合征的作用分子机制研究进展[J]. 中国中药杂志, 2019, 44(23): 5102-5108. (  0) 0) |
| [3] |
谢哲臻. 铁皮石斛试管苗再生体系及抗肿瘤活性研究[D]. 西安: 陕西师范大学, 2012.
(  0) 0) |
| [4] |
汪群红, 何贤君, 鲍珍贝, 等. 不同来源铁皮石斛中多糖、氨基酸和生物碱含量比较[J]. 中药材, 2014, 37(5): 773-775. (  0) 0) |
| [5] |
赵玲琳, 王国荣, 沈伟东, 等. 铁皮石斛炭疽病病原菌的分离鉴定及其有效杀菌剂的筛选[J]. 植物保护, 2018, 44(6): 185-190. (  0) 0) |
| [6] |
WEMHEUER F, WEMHEUER B, DANIEL R, et al. Deciphering bacterial and fungal endophyte communities in leaves of two maple trees with green islands[J]. Sci Rep, 2019, 9(1): 14183. DOI:10.1038/s41598-019-50540-2 (  0) 0) |
| [7] |
崔晋龙, 郭顺星, 肖培根. 内生菌与植物的互作关系及对药用植物的影响[J]. 药学学报, 2017, 52(2): 214-221. (  0) 0) |
| [8] |
王志伟, 纪燕玲, 陈永敢. 植物内生菌研究及其科学意义[J]. 微生物学通报, 2015, 42(2): 349-363. (  0) 0) |
| [9] |
黄璐琦, 张瑞贤. “道地药材”的生物学探讨[J]. 中国药学杂志, 1997, 32(9): 563-566. DOI:10.3321/j.issn:1001-2494.1997.09.019 (  0) 0) |
| [10] |
龚莺, 何伯伟, 王淑珍, 等. 铁皮石斛内生菌研究进展[J]. 浙江农业科学, 2017, 58(8): 1372-1375. (  0) 0) |
| [11] |
刘军, 刘艳明, 徐在超, 等. 檀香内生真菌多样性及其抗菌与促生特性的研究[J]. 中国中药杂志, 2018, 43(17): 3477-3483. (  0) 0) |
| [12] |
程超寰. 本草释名考订[M]. 北京: 中国中医药出版社, 2013.
(  0) 0) |
| [13] |
杨前宇. 兰科菌根真菌多样性研究及其对兰科植物的影响[D]. 北京: 中国林业科学研究院, 2018.
(  0) 0) |
| [14] |
王亚妮. 兰科石斛属植物根部内生真菌多样性研究及应用[D]. 北京: 北京林业大学, 2013.
(  0) 0) |
| [15] |
郭良栋. 内生真菌研究进展[J]. 菌物系统, 2001, 20(l): 148-152. (  0) 0) |
| [16] |
徐丽红, 周鑫, 郑蔚然, 等. 不同仿野生栽培铁皮石斛多品质指标的比较[J]. 浙江农业科学, 2018, 59(7): 1253-1257. (  0) 0) |
| [17] |
江曙, 段金廒, 钱大玮, 等. 根际微生物对药材道地性的影响[J]. 土壤, 2009, 41(3): 344-349. DOI:10.3321/j.issn:0253-9829.2009.03.003 (  0) 0) |
| [18] |
谢华蓉, 徐在超, 刘军, 等. 广藿香内生真菌多样性及其对青枯菌的拮抗活性[J]. 微生物学通报, 2017, 44(5): 1171-1181. (  0) 0) |
| [19] |
BAGY H M M K, HASSAN E A, NAFADY N A, et al. Efficacy of arbuscular mycorrhizal fungi and endophytic strain Epicoccum nigrum ASU11 as biocontrol agents against blackleg disease of potato caused by bacterial strain Pectobacterium carotovora subsp. atrosepticum PHY7
[J]. Biol Control, 2019, 134: 103-113. DOI:10.1016/j.biocontrol.2019.03.005 (  0) 0) |
| [20] |
MARIA C E, ANDREA K, CRISTINA P, et al. Selection of an endophytic Streptomyces sp. strain DEF09 from wheat roots as a biocontrol agent against Fusarium graminearum
[J]. Front Microbiol, 2019, 10: 2356. (  0) 0) |
 2020, Vol. 41
2020, Vol. 41


